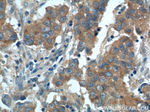
CP110 Antibody in Immunohistochemistry (Paraffin) (IHC (P))
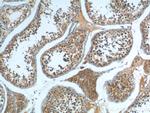
CP110 Antibody in Immunohistochemistry (Paraffin) (IHC (P))

Search
Proteintech
CP110 Polyclonal Antibody
{{$productOrderCtrl.translations['antibody.pdp.commerceCard.promotion.promotions']}}
{{$productOrderCtrl.translations['antibody.pdp.commerceCard.promotion.viewpromo']}}
{{$productOrderCtrl.translations['antibody.pdp.commerceCard.promotion.promocode']}}: {{promo.promoCode}} {{promo.promoTitle}} {{promo.promoDescription}}. {{$productOrderCtrl.translations['antibody.pdp.commerceCard.promotion.learnmore']}}
产品信息
12780-1-AP
种属反应
已发表种属
宿主/亚型
分类
类型
抗原
偶联物
形式
浓度
规格
纯化类型
保存液
内含物
保存条件
运输条件
产品详细信息
Immunogen sequence: MEEYEKFCE KSLARIQEAS LSTESFLPAQ SESISLIRFH GVAILSPLLN IEKRKEMQQE KQKALDVEAR KQVNRKKALL TRVQEILDNV QVRKAPNASD FDQWEMETVY SNSEVRNLNV PATFPNSFPS HTEHSTAAKL DKIAGILPLD NEDQCKTDGI DLARDSEGFN SPKQCDSSNI SHVENEAFPK TSSATPQETL ISDGPFSVNE QQDLPLLAEV IPDPYVMSLQ NLMKKSKEYI EREQSRRSLR GSMNRIVNES HLDKEHDAVE VADCVKEKGQ LTGKHCVSVI PDKPSLNKSN VLLQGASTQA SSMSMPVLAS FSKVDIPIRT GHPTVLES (1-337 aa encoded by BC036654)
靶标信息
Necessary for centrosome duplication at different stages of procentriole formation. Acts as a key negative regulator of ciliogenesis in collaboration with CEP97 by capping the mother centriole thereby preventing cilia formation (PubMed:17719545 PubMed:17681131, PubMed:23486064). Also involved in promoting ciliogenesis. May play a role in the assembly of the mother centriole subdistal appendages (SDA) thereby effecting the fusion of recycling endosomes to basal bodies during cilia formation. Required for correct spindle formation and has a role in regulating cytokinesis and genome stability via cooperation with CALM1 and CETN2 (PubMed:16760425). [UniProt]
仅用于科研。不用于诊断过程。未经明确授权不得转售。
生物信息学
蛋白别名: centriolar coiled-coil protein 110kDa; Centriolar coiled-coil protein of 110 kDa; Centriolin; centrosomal protein CP110; Centrosomal protein of 110 kDa; CEP1; Cep110; CNTRL; CP110; FAN; KIAA0419; unnamed protein product
基因别名: 6330503K22Rik; AA415922; AI427129; AW557948; CCP110; CEP110; CP110; KIAA0419; RGD1310509
UniProt ID: (Human) O43303, (Mouse) Q7TSH4
Entrez Gene ID: (Human) 9738, (Dog) 479826, (Mouse) 101565, (Rat) 361634